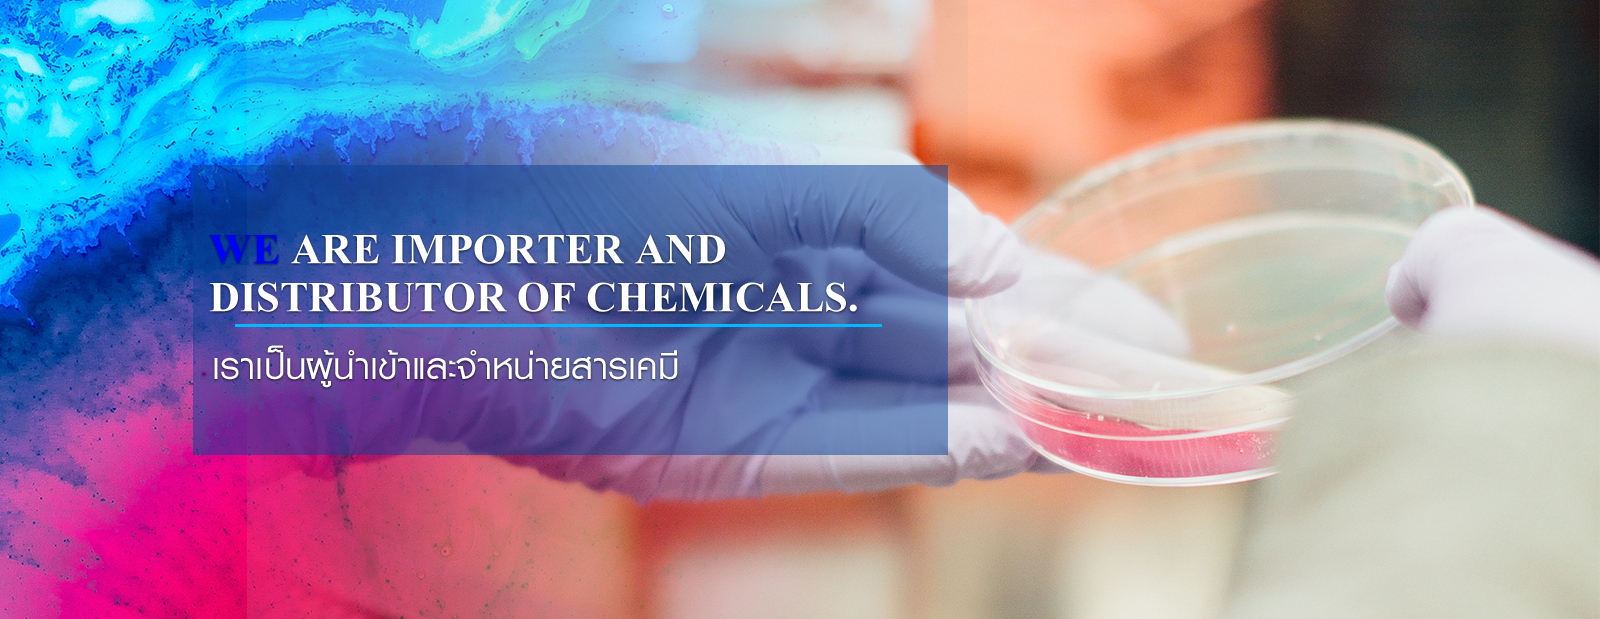

We are committed to providing excellent customer service and to
delivering products that satisfy customer needs.
 เราให้มุ่งมั่นจะให้บริการที่ดี
เราให้มุ่งมั่นจะให้บริการที่ดีและนำเสนอสินค้าที่ตอบสนองความต้องการของลูกค้า

We are committed to providing excellent customer service and to
delivering products that satisfy customer needs.
 เราให้มุ่งมั่นจะให้บริการที่ดี
เราให้มุ่งมั่นจะให้บริการที่ดีและนำเสนอสินค้าที่ตอบสนองความต้องการของลูกค้า

We are importer and distributor of chemicals.
เราเป็นผู้นำเข้าและจำหน่ายสารเคมี
© Copyright 2018 www.bifrostchemicals.com Powered by บ้านเว็บไซต์

Tel. :
Tel. :  Fax. :
Fax. :  อีเมล :
อีเมล : 


